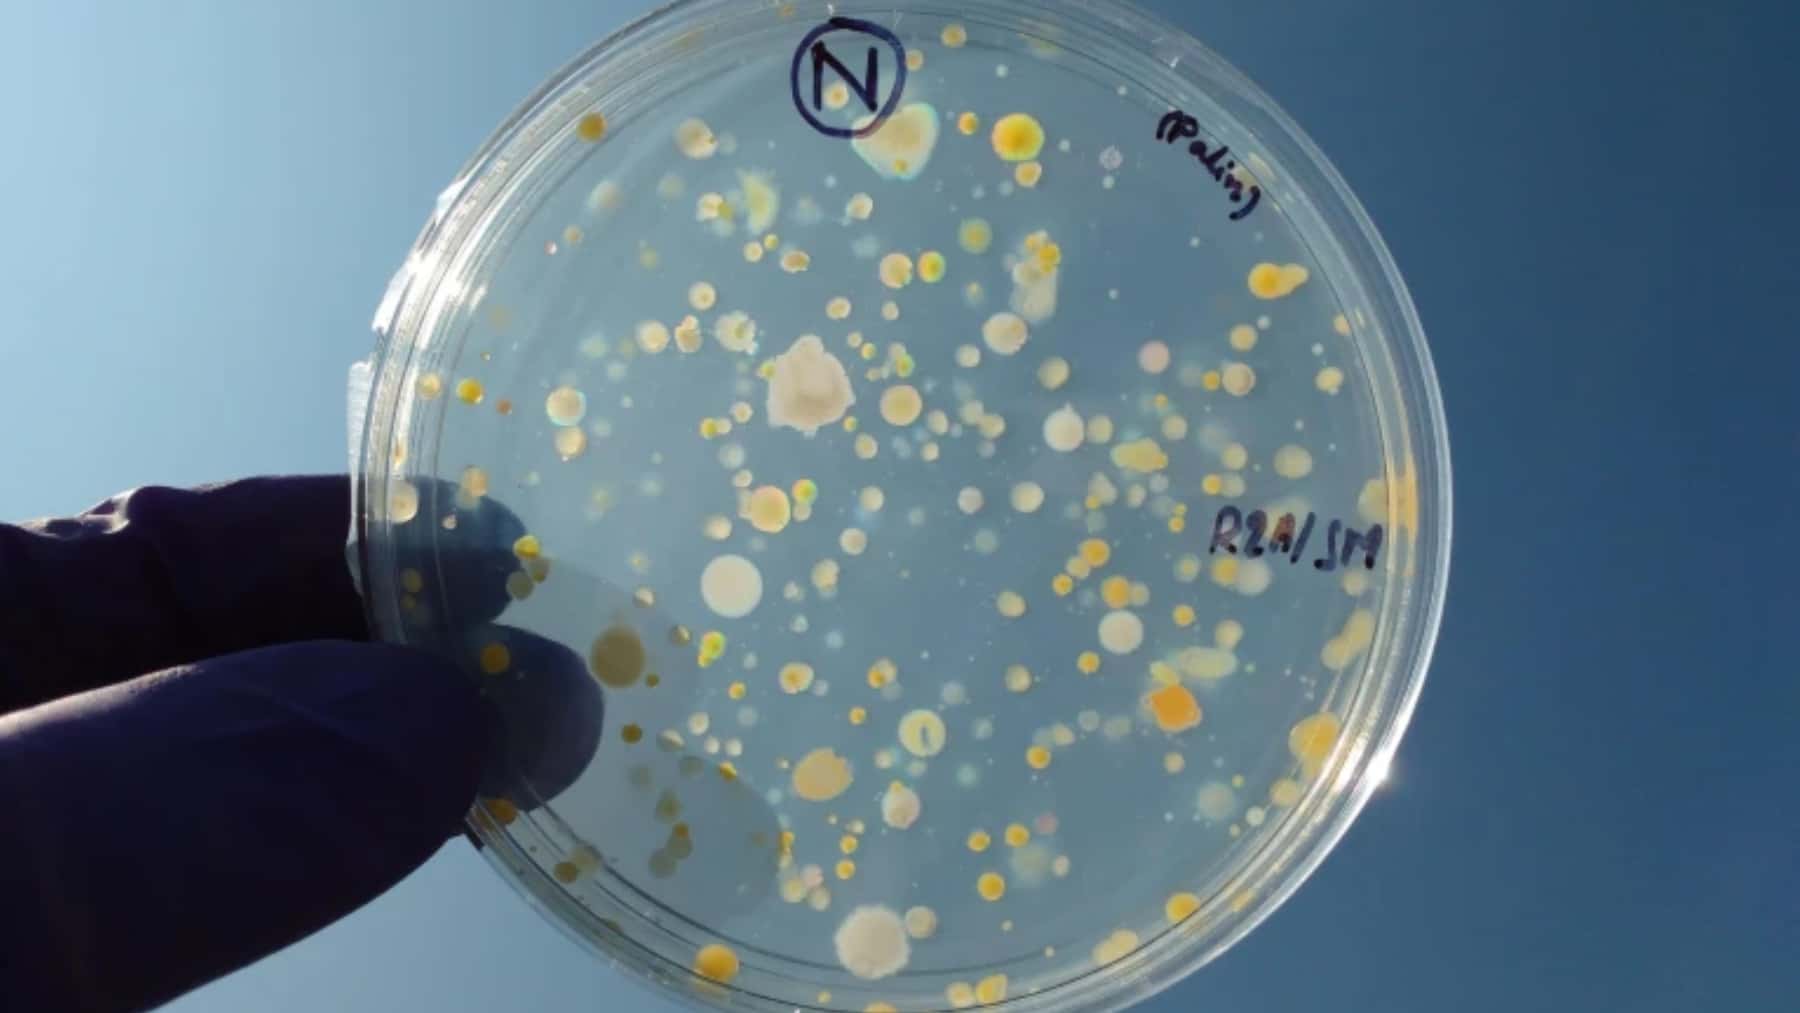
Placa de Petri con colonias bacterianas de distintos tamaños sostenida con una mano enguantada

Han hecho falta seis millones de galaxias y cuásares, once mil millones de años de historia cósmica y 5.000 “ojos robóticos” apuntando al cielo desde Arizona para responder a una pregunta aparentemente simple: ¿seguía teniendo razón Einstein? La respuesta, de momento, es que sí.
Un equipo internacional de más de 900 investigadores, coordinado por el Lawrence Berkeley National Laboratory del Departamento de Energía de Estados Unidos, ha presentado el que se considera el mayor examen de la gravedad realizado hasta la fecha. Lo han hecho con los datos del Dark Energy Spectroscopic Instrument (DESI), instalado en el telescopio Mayall de 4 metros del Observatorio Nacional de Kitt Peak, y los resultados encajan, en gran medida, con lo que la relatividad general predice según recoge el medio Phys.
Por qué este examen era necesario
La teoría que Albert Einstein publicó en 1915 lleva más de un siglo superando pruebas. El problema es que casi todas se han realizado en entornos relativamente pequeños: el Sistema Solar, estrellas binarias, pulsares. A escalas de miles de millones de años luz, había mucho margen para que la gravedad se comportara de forma distinta a la esperada.
Y ahí es donde entra DESI. El instrumento, capaz de capturar la luz de 5.000 galaxias a la vez, lleva desde 2019 levantando el mapa tridimensional más grande del universo. Con un solo año de datos, su equipo ha analizado cómo se agrupan los cúmulos galácticos a lo largo de la llamada “red cósmica” y ha comparado esa distribución con lo que la relatividad general anticipa.
“La relatividad general ha sido muy bien contrastada a escala del sistema solar, pero también necesitábamos comprobar que nuestra suposición funciona a escalas mucho mayores”, explicó la cosmóloga Pauline Zarrouk, del CNRS francés. El resultado, según ella, alinea las observaciones con lo que la teoría de Einstein predice a escalas cosmológicas.
Qué se mide exactamente
El análisis se llama “full-shape analysis” y amplía un estudio anterior de abril de 2024 centrado en las oscilaciones acústicas bariónicas (BAO), esas huellas dejadas por las ondas sonoras del universo primitivo. La novedad ahora es que los investigadores han medido cómo se distribuye la materia a diferentes escalas, no solo en un rango concreto. En la práctica, eso significa poner a prueba la gravedad con una lupa mucho más fina.
Para evitar cualquier sesgo, el equipo usó una técnica de “ciego”: ocultaron el resultado final hasta el último momento. Meses de verificaciones cruzadas después, los números cuadraban.
Materia oscura, energía oscura y los cabos sueltos
Confirmar a Einstein no resuelve, sin embargo, los grandes misterios del cosmos. La gravedad explica cómo se agrupan las galaxias, pero no por qué el universo acelera su expansión ni qué es exactamente la materia oscura. Los datos de DESI, de hecho, apuntan a algo curioso: la energía oscura podría estar evolucionando con el tiempo, en lugar de ser una constante inmutable.
“Nuestros datos de DESI coinciden con la teoría de la gravedad de Einstein, pero siguen favoreciendo una energía oscura dinámica, y encontrar ambas cosas a la vez es algo nuevo”, señaló el astrofísico Mustapha Ishak-Boushaki, de la Universidad de Texas en Dallas y codirector del estudio.
El trabajo también ha estrechado el cerco sobre la masa de los neutrinos, las partículas elementales más escurridizas. Según los nuevos cálculos, la suma de las masas de los tres tipos conocidos debe ser inferior a 0,071 electronvoltios, frente a un mínimo previo de 0,059.
Lo que viene después
DESI está en su cuarto año de operación. Cuando termine, habrá observado unos 40 millones de galaxias y cuásares. Los datos de los años dos y tres se esperaban para la primavera de 2025, y podrían ajustar aún más los resultados.
¿Significa esto que Einstein es intocable? No exactamente. Los propios investigadores recuerdan que la relatividad general falla al intentar conciliarse con la mecánica cuántica, y que en algún punto tendrá que ceder. Por ahora, eso sí, el universo a gran escala sigue funcionando como él lo imaginó hace más de cien años.
En el siguiente enlace se puede leer el paper del estudio.